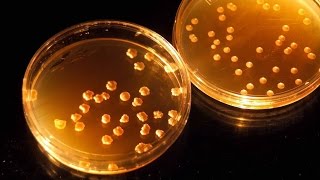
NASA Granted $200k/Year for Recycling Human Poop Into Food

Song info
"Disposal Of Human Garbage"
(2007)
0 người yêu thích
"Disposal Of Human Garbage" Videos
Lyrics
Oh! We don't have the lyrics to this song yet.
- 0 Bản dịch
Albums has song "Disposal Of Human Garbage"

Singles
55 songs
- Fag Killer 2007
- Eat My Fuck 2007
- Cum On Your Fucking Face 2007
- Runaway Sex-Slave 2007
- Would You Please Die? 2007
- Bow To The Penis-God 2007
- Intelligence Refused 2007
- Fornication 2007
- In You ... I Cum 2007
- Excrement Infection Of The Male Urethra 2007
- Elvis ... Is Still Dead 2007
- She Likes It Hard 2007
- Ejaculation Evacuation 2007
- Strenuous Fuck 2007
- Act Of Love 2007
- The End 2007
- Forbidden Fruit 2007
- Forced Into Submission 2007
- The Devil Made Me Do It 2007
- First Blow-Job 2007
- Bulimic Excretion 2007
- Hairless But Hard 2007
- Ignorance... Is Bliss 2007
- F.B.M. (Fag Bashing Mania) 2007
- Disposal Of Human Garbage 2007
- I Shit On Your Grave 2007
- She Never Says No 2007
- There Is No God 2007
- Septic Jesus 2007
- Finger Fuck Surprise 2007
- Isolated And Gang Raped 2007
- Surgically Removed Vagina 2007
- Perverted Vengeance 2007
- Hermaphrodite Nightmare 2007
- Poor Feminine Hygiene 2007
- Bathe In Holy Excrement 2007
- Revenge On A World Full Of Cunts 2007
- A.C. (Anal Cunt) 2007
- Manipulation Of Mankind 2007
- Meat Rabbit 2007
- Anal Quickie / Act Of Hate 2007
- Orgasmic Euphoria 2007
- Don't Have A Nice Day 2007
- Orgasm Of Cardiac Arrest 2007
- Bloodbath Cleansing 2007
- Mental Midget 2007
- Depravity 2007
- Menstrual Blood Lust 2007
- Ecstasy Of Death 2007
- Violent Outburst Of Sodomy 2007
- Cock-Rock Faggots 2007
- Three Way Fuck 2007
- Cocaine Cunt Numb 2007
- Sex-Life (Dub Mix) 2007
- Children Of Rape 2007

Singles
55 songs
- Fag Killer 2007
- Eat My Fuck 2007
- Cum On Your Fucking Face 2007
- Runaway Sex-Slave 2007
- Would You Please Die? 2007
- Bow To The Penis-God 2007
- Intelligence Refused 2007
- Fornication 2007
- In You ... I Cum 2007
- Excrement Infection Of The Male Urethra 2007
- Elvis ... Is Still Dead 2007
- She Likes It Hard 2007
- Ejaculation Evacuation 2007
- Strenuous Fuck 2007
- Act Of Love 2007
- The End 2007
- Forbidden Fruit 2007
- Forced Into Submission 2007
- The Devil Made Me Do It 2007
- First Blow-Job 2007
- Bulimic Excretion 2007
- Hairless But Hard 2007
- Ignorance... Is Bliss 2007
- F.B.M. (Fag Bashing Mania) 2007
- Disposal Of Human Garbage 2007
- I Shit On Your Grave 2007
- She Never Says No 2007
- There Is No God 2007
- Septic Jesus 2007
- Finger Fuck Surprise 2007
- Isolated And Gang Raped 2007
- Surgically Removed Vagina 2007
- Perverted Vengeance 2007
- Hermaphrodite Nightmare 2007
- Poor Feminine Hygiene 2007
- Bathe In Holy Excrement 2007
- Revenge On A World Full Of Cunts 2007
- A.C. (Anal Cunt) 2007
- Manipulation Of Mankind 2007
- Meat Rabbit 2007
- Anal Quickie / Act Of Hate 2007
- Orgasmic Euphoria 2007
- Don't Have A Nice Day 2007
- Orgasm Of Cardiac Arrest 2007
- Bloodbath Cleansing 2007
- Mental Midget 2007
- Depravity 2007
- Menstrual Blood Lust 2007
- Ecstasy Of Death 2007
- Violent Outburst Of Sodomy 2007
- Cock-Rock Faggots 2007
- Three Way Fuck 2007
- Cocaine Cunt Numb 2007
- Sex-Life (Dub Mix) 2007
- Children Of Rape 2007

Recent comments